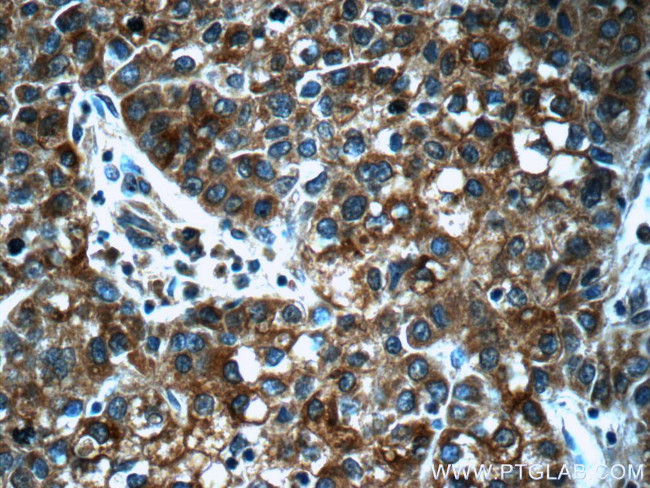
Secretin Antibody in Immunohistochemistry (Paraffin) (IHC (P))
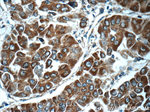
Secretin Antibody in Immunohistochemistry (Paraffin) (IHC (P))

Search
Proteintech
Secretin Polyclonal Antibody
{{$productOrderCtrl.translations['antibody.pdp.commerceCard.promotion.promotions']}}
{{$productOrderCtrl.translations['antibody.pdp.commerceCard.promotion.viewpromo']}}
{{$productOrderCtrl.translations['antibody.pdp.commerceCard.promotion.promocode']}}: {{promo.promoCode}} {{promo.promoTitle}} {{promo.promoDescription}}. {{$productOrderCtrl.translations['antibody.pdp.commerceCard.promotion.learnmore']}}
产品信息
23125-1-AP
种属反应
宿主/亚型
分类
类型
抗原
偶联物
形式
浓度
规格
纯化类型
保存液
内含物
保存条件
运输条件
产品详细信息
Immunogen sequence: ARRHSDGTF TSELSRLREG ARLQRLLQGL VGKRSEQDAE NSMAWTRLSA GLLCPSGSNM PILQAWMPLD GTWSPWLPPG PMVSEPAGAA AEGTLRPR (25-121 aa encoded by BC146571 )
靶标信息
Secretin belongs to the glucagon family. This protein is an endocrine hormone and its major site of production is the endocrine S cells located in the proximal small intestinal mucosa. The release of active secretin is stimulated by either fatty acids or an acidic pH in the duodenum. This hormone stimulates the secretion of bicarbonate-rich pancreatic fluids and has also been shown to regulate the growth and development of the stomach, small intestine, and pancreas. Secretin deficiency has been implicated in autistic syndrome, suggesting that the hormone could have a neuroendocrine function in addition to its role in digestion.
仅用于科研。不用于诊断过程。未经明确授权不得转售。